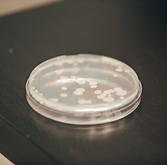
_Y9A3182.jpeg

Odor Control
The Science

The sewer network is the conduit for transporting wastewater from various sources to the wastewater treatment plant (WWTP). Research has shown that it can be utilized as a biological reactor similar to bioreactors in the WWTP, which can change the influent wastewater quality and reduce the influent load to the WWTP (Nielsen et al., 1992; Tanaka & Hvitved-Jacobsen, 1998). The biochemical transformations in the sewer are initiated by microorganisms (mainly dominated by heterotrophic bacteria) (Hvitved-Jacobsen, 2002). The most important processes are the hydrolysis of hydrolysable substrates (i.e., organics or chemical oxygen demand) and the utilization of a readily biodegradable substrate (Nielsen et al., 1992; Hvitved-Jacobsen, 2002; Gavalakis et al., 2006). The environment in sewer network can be simplified as the bulk water phase, the biofilm phase, the biofilm/sediment phase and the sewer atmosphere as shown in figure 1.

figure 1.
Microbial processes (i.e., fermentation, respiration, and hydrolysis of the hydrolysable substrate) are carried out in the bulk water phase, the biofilm phase, and the biofilm/sediment phase in the sewer (Jahn et al., 1998). The Sewer atmosphere is the source of oxygen for aerobic microbial respiration and microbial metabolic byproducts.
Biofilms are composed of cells embedded with an extracellular polymeric substance (EPS), a mixture of protein, polysaccharides, nucleic acids, humic substances, lipids, and other molecules (Nielsen et al., 1997), which is a sticky organic matter produced by microbes and responsible for cell adhesion to surfaces as biofilms (Wolfaardt et al., 1999). Three distinct layers of aerobic, anoxic, and anaerobic conditions exist within the biofilm and separate conversion processes occur within each layer (Hao et al., 1994).

How IPT Treatment Works
While many bacteria in the collection system (and the WWTP) respire strictly aerobically or strictly anaerobically, IPT Bacillus formulations are facultative microbes that respire[1] using nitrate or nitrite as the electron acceptor under anoxic conditions, oxygen as an electron acceptor under aerobic conditions, or grow by fermentation in the absence of electron acceptors (Ye et al., 2000; Nakano et al., 1998).
IPT’s approach adds microbial activity in addition to the indigenous bacteria (bulk phase and biofilm) such that more reactions occur in the sewer that contribute to enhanced conversion or degradation of wastewater compounds within the sewer. The addition of Bacillus allows a gradual repopulation of the collection system (i.e., established beneficial bulk and biofilm phase bacteria) that are more resistant to changing environmental conditions and efficient at degradation of organics than the bacteria that are present in natural, untreated conditions (Gerardi, 2006; Morikawa 2006; Mongkolthanaruk et al., 2002; Wattiau et al., 2001).
[1] Respiration is the metabolic process in which microorganisms use exogenous electron acceptors (i.e., oxygen, nitrate, nitrite etc) to obtain energy. Fermentation differs from respiration in that microorganisms use endogenous electron acceptors (usually organics) to extract energy (Gerardi, 2006).
Methodology
The microbiological treatment for a collection system is carefully engineered and driven by factors such as organic loads, distribution, collection system layout, and treatment objectives. Continual addition, twenty-four hours per day, seven days a week (24/7), to the outer reaches of the wastewater collection system allow IPT bacteria to grow throughout the bulk water and biofilm phase, improving the ability of the collection system to degrade and/or convert the organic material by taking advantage of the residence time of the wastewater within the sewer (Tanaka et al., 1998; Hvitved-Jacobsen, 2002; Gavalaki et al., 2003).
To utilize the collection system as an active part of the wastewater treatment process, significant biofilm coverage of the interior surface area of the infrastructure is required. Influent wastewater quality changes and thus operational changes at the plant are expected. Changes typically develop between 30 and 60 days after implementation because of the time required displacing the wild biofilm in the collection system.
In fact, Bacillus bacteria in IPT formulations are common soil bacteria but are not normally found in significant concentrations in wastewater. Bacilli found in the wastewater in the collection system primarily are due to infiltration and surface run off; however, the quantity is insufficient to positively impact wastewater treatment. In-Pipe formulations contain very high concentrations of select strains continuously added to establish bacterial dominance, broadening the microbial diversity present in the wastewater, which provides for better processing of the materials present in the wastewater.

Figure 2. FISH study of Kennedy House biofilm samples using different probes. FISH results for samples collected (A) March 28th (pre-bioaugmentation), (B) April 4th (with bioaugmentation) (C) June 27th (with bioaugmentation) and (D) July 11th (with bioaugmentation). Each image is a merged image of the DAPI stained cells (blue) and cells containing the identifiers of IPT bacteria (red). Zoomed-in detail of insets (dashed boxes) are below each image. Size bars equal to 10 µm.
Bacteria in Competition
​
The biological principal of Competitive Exclusion can be viewed in two ways:​
1
As microbes multiply in numbers much higher than others that compete for the same nutrients; and
2
Where certain microbes have tools (e.g. antibiotics and toxins) that allow them to repel, damage or kill indigenous microorganisms.
To out-compete anaerobic bacteria from the human gastrointestinal tract entering the sewer, IPT introduces blend of specialized, facultative, spore forming bacteria up to 108 times greater than indigenous sessile bacteria in wastewater. Bacillus bacteria also produce antimicrobial compounds and toxins such as surfactin, polymyxin, difficidin, subtilin, mycobacillin, and subtilosin, with a range of activity against fungus and both aerobic and anaerobic gram-positive or gram-negative bacteria (Shelburne et al., 2007).
In a study conducted by In-Pipe Technology in collaboration with Dr. Peter Stroot at the University of South Florida – Tampa, FISH (Fluorescent In-Situ Hybridization) analysis was conducted prior to IPT bioaugmentation and with IPT bioaugmentation. Analysis of FISH images (Figure 2) confirmed a significant increase of Bacillus in the collection system biofilm with IPT bioaugmentation. The the microbial community of the sample sites was altered by out-competing the native microorganisms for nutrients. The abundance of Bacillus was maintained several months after the initiation our service. Data determined that Bacillus established themselves within the microbial communities, and hydrogen sulfide production decreased ~65- 100%.
Operating Characteristics
Temperature and pH
IPT bacteria grow over a wide temperature range (5-55 oC). The optimal growth occurs between 20 to 37 oC, although In-Pipe projects are located in climates where temperatures vary between 3oC to 40 oC. Our blends contain isopropyl alcohol (IPA) which prohibits freezing. The functionality of our Microbial Dosing Units (MDUs) is not compromised by changes in temperature. The optimal pH range for In-Pipe bacteria is 6.5 – 8.
Wastewater Flow and Velocity
​
Biofilm growth and substrate utilization (or conversion) depends on the sewer environment, configuration, and the wastewater residence time (i.e., velocities within the sewer). For a gravity sewer, if the wastewater velocity is high (i.e., steeply sloped), there will be minimal coverage of the pipe surface area with biofilm. In conditions where the flow is slow (i.e., minor slope) more pipe surface area will be covered with biofilm (Bjerre 1998). Both conditions allow IPT bacteria to augment the biofilm; however, due to the low resident time with high flow rate, the biochemical conversion will be less compared with low flow rate condition. For force mains, sewer environments are completely anaerobic, typically with a thriving community of Sulfate-Reducing Bacteria (SRBs). Compared to gravity sewers, the process of competitive exclusion will be slower, so will therefore will require an aggressive dosing plan.
Hydrogen sulfide is an odorous, toxic gas. In the absence of dissolved oxygen (DO) and in the presence of soluble Biological Oxygen Demand (BOD), Desulfovibrio desulfuricans and other sulfate-reducing bacteria convert the sulfate to sulfide (Gibson et al, 1991). In the absence of sulfate, certain strains of SRB can use a single carbon compound as both the electron donor and an electron acceptor by a process called dismutation (Meyers, 1995). The SRB’s are generally thought to be obligate anaerobes but recently it has been determined that they can tolerate oxygen for short periods of time and even proliferate in the presence of oxygen (Cypionka, 2000). Several of these types of bacteria are commonly found in the human colon, such as desulfovibrio and desulfobacter (Gibson et al, 1991).
Under conditions with very low or nonexistent free molecular oxygen available, anaerobic bacteria use nitrate-bound oxygen (NO3) as a final electron acceptor. If there is no nitrate available they will use sulfate-bound oxygen (SO4) as a final electron acceptor which releases sulfide ions into the wastewater (Gerardi, 2006). The sulfide ions associate with free hydrogen ions in the water and form hydrogen sulfide gas, which occupies the headspace of the piping. The hydrogen sulfide gas in the pipe headspace is oxidized to sulfuric acid by hydrogen sulfide- oxidizing bacteria existing on the inner surface of the headspace piping. This sulfuric acid is created constantly in the presence of hydrogen sulfide gas and is highly corrosive to many common piping materials, including steel, ductile iron and concrete (Metcalf & Eddy, 2003).

figure 3.
It is clearly evident that a means to detect, control, and correct hydrogen sulfide corrosion in existing wastewater systems is the preferred alternative to premature replacement of system components (EPA 1991). Several methods available to control the rate of hydrogen sulfide corrosion focus on chemical injections. The most common chemical alternatives are costly and, in some cases, hazardous. Chemicals are feed at limited locations where the problems are generally the most severe; however, within a network of sewers that transports wastewater over thousands of square feet of collection system infrastructure only a small portion of the sewer is protected.
In a study of IPT’s approach conducted by Dr. Eberhard Morgenroth of the University of Illinois, a molecular analysis was performed on biofilm with In- Pipe bacteria using Terminal Restriction Fragment Length Polymorphism (T-RFLP). The study identified a shift in the dominant populations of microorganisms that decreased dissolved sulfides 50% after continuous addition for 20 days from 0.45 mg/l to 0.23mg/l. The reason is largely due to bacteria that are more flexible to convert organic matter that allow gradual repopulation of the biofilm and prevents the proliferation of SRBs.
In-Pipe performance has consistently lower solution sulfides in field measurements using a Hach total sulfide test kit. Monitoring atmospheric hydrogen sulfide is less consistent; however, specific variables related to the target monitoring location generally require explanation. Figure 3 shows performance in Plymouth, MA compared to Bioxide, a common chemical additive used to control H2S.

